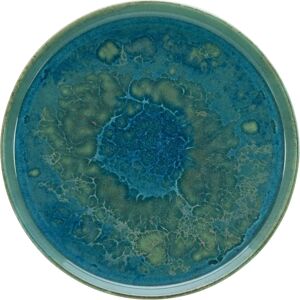
Creatable Yuki 28cm Groen Blauw Bord - Dinner Plate Creatable Yuki 28cm Groen Blauw Bord - Dinner Plate

Aanbiedingen bijgewerkt op: 2-4-2026. Betaalde en niet-uitputtende advertenties. ★ De beoordelingen zijn gegenereerd uit meerdere bronnen, waaronder gegevens verstrekt door de handelaar en openbaar beschikbare informatie.
Vanwege technische beperkingen kan Kelkoo de volledige nauwkeurigheid en volledigheid van de door de verkopers verstrekte informatie niet garanderen. Als gevolg, en vanwege de aard van de activiteiten van Kelkoo, zullen in geval van verschillen tussen de informatie die op de Kelkoo-website wordt weergegeven en die op de website van de handelaar wordt getoond, de laatste prevaleren. Getoonde prijzen zijn inclusief alle kosten, behalve voor nieuwe voertuigen (prijs incl. Btw en zonder aanbetalingskosten) - Learn more